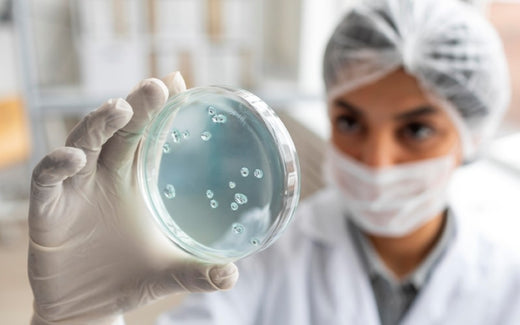
A Reliable Source for High-Quality Petri Dishes

Trusted Australian Manufacturer
For over 35 years, Techno Plas, a leading Australian company, has been a trusted partner in the scientific community. Our state-of-the-art facility in St Mary's, SA, utilizes 24/7 automated injection moulding to ensure consistent quality, timely delivery, and cost-effective solutions. They are constantly reinvesting in and upgrading our equipment to stay at the forefront of technology.
Techno Plas Petri Dishes: The Perfect Choice for Microbiological Testing
Techno Plas offers a comprehensive range of petri dishes designed to meet the diverse needs of laboratories across various industries, including food safety, healthcare, research, and academia. The petri dishes are perfect for:
Microbiological Testing: Ideal for cultivating and analysing microorganisms such as bacteria, fungi, and yeast.
Efficient Sample Handling: Available in full-plate (14 x 90mm) and half-plate options, cater to your specific workflow requirements.
Optimal Airflow and Sample Incubation: The triple-vented design ensures proper air circulation, critical for successful microorganism growth.
Full Plate Petri Dishes
Full-plate petri dishes are crafted from durable polystyrene and feature a space-saving stackable design with a convenient stacking ring. These dishes come in packs of 20, pre-sterilized and heat-sealed for sterility and user safety.
Half Plate Petri Dishes
Techno Plas also offers a half-plate petri dish option. Made with the same commitment to quality and convenience as our full-plate dishes, these space-saving options are ideal for optimized workflow and efficient sample handling. Like the full-plate option, they are heat-sealed in packs of 20 for guaranteed sterility.
Benefits of Techno Plas Petri Dishes
Crystal Clarity: The high clarity of our polystyrene petri dishes allows for unobstructed sample visualization.
Leak-Proof Design: The secure lids prevent spills and contamination, safeguarding your samples.
Cost-Competitive: Techno Plas provides high-quality petri dishes at affordable prices.
Explore Techno Plas petri dishes enhance your workflow and contribute to successful microbiological testing endeavours.
Facilitate your Lab workflow, explore the Petri Dishes range from Techno Plas HERE.